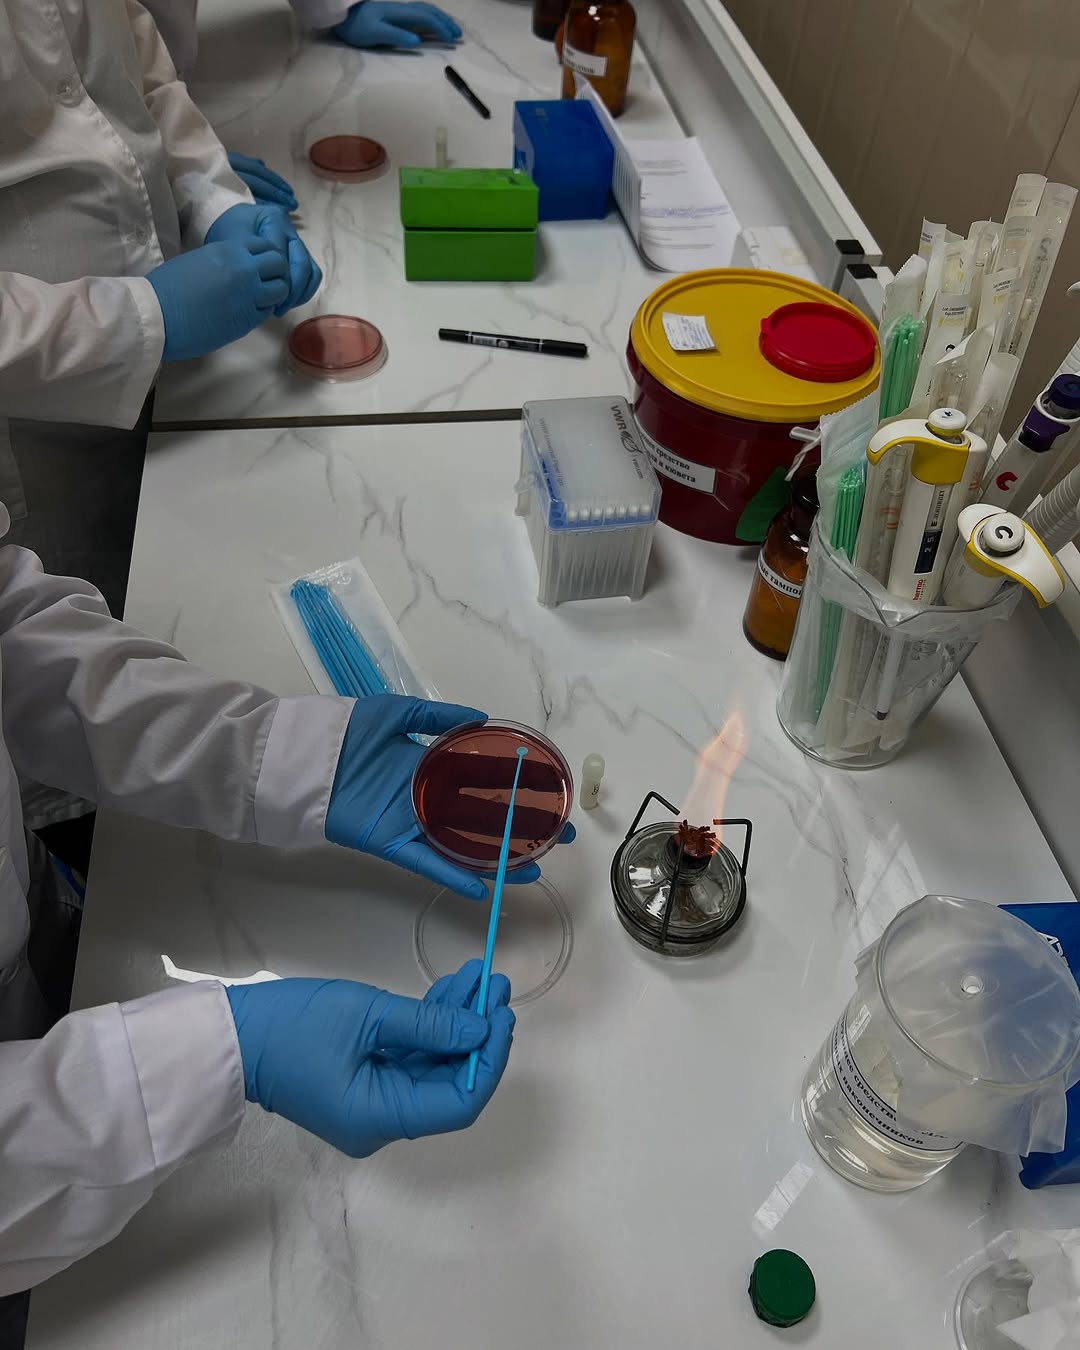
Фото 16

Обучение проводится в рамках проекта Продовольственной и сельскохозяйственной организации ООН (ФАО) и Пандемического фонда «Готовность к пандемии и ответные меры на основе подхода “Единое здоровье» в Центральной Азии» при поддержке Республиканской ветеринарной лаборатории.
Тренинг представляет собой совместную инициативу ФАО и РВЛ и включает теоретические и практические занятия по международным стандартам EUCAST. Основная цель — развитие профессиональных компетенций в области лабораторного мониторинга антимикробной резистентности (АМР) в ветеринарии.
В числе участников — специалисты Республиканской ветеринарной лаборатории и Национального референтного центра по ветеринарии. Обучение проводят международный эксперт ФАО Франческа Латроникo (Италия) и национальный эксперт Лейла Ансабаева.
Проведение тренинга стало значимым шагом в развитии устойчивой лабораторной системы АМР-надзора в Казахстане. Первый руководитель РГП «РВЛ» Елшибаев Т.А. поддерживает инициативу и подчёркивает важность постоянного повышения квалификации специалистов как ключевого элемента эффективной ветеринарной системы.